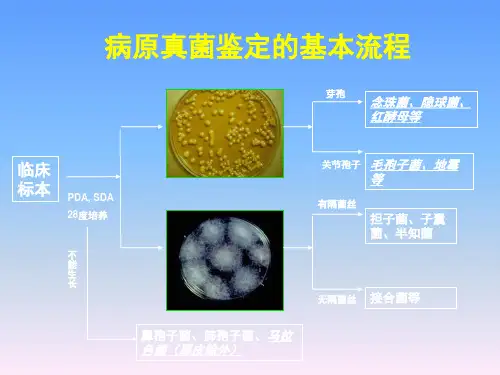

常见真菌的分离与鉴定
- 格式:doc
- 大小:68.50 KB
- 文档页数:11

树木共生真菌菌株纯化及快速鉴定方法下载提示:该文档是本店铺精心编制而成的,希望大家下载后,能够帮助大家解决实际问题。
文档下载后可定制修改,请根据实际需要进行调整和使用,谢谢!本店铺为大家提供各种类型的实用资料,如教育随笔、日记赏析、句子摘抄、古诗大全、经典美文、话题作文、工作总结、词语解析、文案摘录、其他资料等等,想了解不同资料格式和写法,敬请关注!Download tips: This document is carefully compiled by this editor. I hope that after you download it, it can help you solve practical problems. The document can be customized and modified after downloading, please adjust and use it according to actual needs, thank you! In addition, this shop provides you with various types of practical materials, such as educational essays, diary appreciation, sentence excerpts, ancient poems, classic articles, topic composition, work summary, word parsing, copy excerpts, other materials and so on, want to know different data formats and writing methods, please pay attention!在研究树木共生真菌的纯化和鉴定过程中,可以利用一些快速有效的方法来进行实验,以下将介绍其中的一些步骤和技巧。



实验五真菌的分离培养及形态观察真菌分离培养应考虑所分离真菌的特性,配制合适的培养基,选择所需的气体环境。
同时, 由于真菌分离材料常污染有大量细菌,所以可在培养基中加入抗菌素并在分离培养过程中严格执行无菌操作。
目的要求1.掌握真菌分离培养方法。
2.认识真菌菌落的特征,比较与细菌菌落有何不同。
3.了解真菌载片培养法。
4.掌握观察真菌的基本方法,并观察其形态特征。
操作步骤—、真菌的分离培养方法(-)平板划线分离法1.取适合真菌的琼脂培养基融化,冷至45℃,注入无菌平皿中,每皿15~20ml,制成平板待用。
2.取要分离的材料(如田土、混杂的或污染的真菌培养物、真菌)少许,投入盛无菌水的试管内,振摇,使分离菌悬浮于水中。
3.将接种环经火焰灭菌并冷却后,蘸取上述菌悬浮液,进行平板划线(同细菌的划线法)。
4.划线完毕,置温箱中培养2~5d,待长出菌落后,钓取可疑单个菌落先作制片检查,若只有一种所需要的真菌生长,即可进行钓菌纯培养。
如有杂菌可从单个菌落中钓少许菌制成悬液,再作划线分离培养,有时需反复多次,才得纯种。
另外,也可在放大镜的观察下,用无菌镊子夹取一段待分离的真菌菌丝,直接放在平板上作分离培养,可获得该种真菌的纯培养。
(二)稀释分离法1.取盛有无菌水的试管5支(每管9ml),分别标记1、2、3、4、5号。
取样品(如田土等)1g,投入1号管内,振摇,使悬浮均匀。
2.用1ml灭菌吸管,按无菌操作法,从1号管中吸取1ml悬浮液注入2号管中,并摇匀;同样由2号管取1ml至3号管,依此类推,直至5号管。
注意每稀释一管应更换一支灭菌吸管。
3.用2支无菌吸管分别由4号、5号试管中各取1ml悬液,并分别注入2个灭菌培养皿中,再加入融化后冷至45℃的琼脂培养基约15ml,轻轻在桌面上摇转,静置,使冷凝成平板。
然后倒置温箱中培养,2~5d后,从中挑选单个菌落,并移植于斜面上。
二.真菌培养性状观察(一)真菌在固体培养基上的生长表现1 .酵母菌菌落:酵母菌在固体培养基上多呈油脂状或蜡脂状,表面光滑、湿润、黏稠,有的表面呈粉粒状、粗糙或皱褶。


常用的几种典型的病原菌分离方法1.斑点病原菌的分离从病斑部分切取每边3~5 mm的小块组织,在70%酒精中浸数秒钟后,移入0.1%的升汞水溶液中处理3~5 min,以灭菌水冲洗3次,移置培养皿的培养基中,然后培养。
2.维管束组织内病原菌的分离从根茎维管束组织分离病菌,可先将寄主病部表面用70%酒精擦拭消毒,将表皮组织用灭菌的解剖刀削去,然后切取其中小块变色的维管束组织,用升汞或漂白粉液消毒后。
,用灭菌水冲洗几次,移置培养基面上。
3.根腐病病原菌的分离根腐或基腐病的分离,由材料的大小决定。
材料小的可仿照斑点病的分离法,材料大的则可以用维管束组织内病原的分离法。
4.肉质组织中病原菌的分离多肉的根、茎及果实等,可以采用维管束组织内病菌分离法除去表面组织,切取小块病组织分离。
如有杂菌感染可采用“直接接种”法,待出现症状后,用此法再行分离。
5.种子内病原菌分离将整个种子或者种子的一部分进行表面消毒(升汞或漂白粉),用灭菌水洗涤后,移置培养基上。
6.孢子分离法能产生大量孢子的病菌如青霉素、链格孢等,则可配制成孢子悬浮液以稀释法或划线法分离之。
7、土壤带菌分离法为了研究一些真菌在土壤中存活和分布的情形,从有病的土壤中分离它们是必要的。
分离方法是将土壤取出少许,配制成悬浮液,然后用稀释法或划线法分离。
附录2 真菌单孢子分离技术一、目的要求了解单孢分离技术的基本原理,掌握简便实用的单孢分离方法。
二、基本原理单孢分离的方法很多,如振落法、稀释法和直接挑取法。
振落法和稀释法的共同点都是采用某种方法,使真菌孢子较稀疏地分散在水琼脂平板上,然后在显微镜下检查寻找在水琼脂平板表面的单个孢子,一旦找到理想的单个孢子,就通过无菌操作将其(连同一部分培养基)移植到PDA斜面培养基上,置适温下培养,形成的菌落即为单孢系菌株。
直接挑取法是在实体解剖镜下直接挑取单个孢子进行分离纯化的方法。
三、材料、用具与仪器1.材料(依本地资源情况进行选择,下列材料供参考)(1) 稻瘟病叶、病节、病穗颈(Pyricolaria oryzae)。


真菌的鉴定及药敏试验分析真菌对人类健康的危害包括由病原性真菌、条件致病真菌所致的深部真菌病和浅部真菌病;由气传真菌所致的变态反应真菌症即过敏;由污染真菌产毒所致的真菌中毒症。
随着医学的发展,特别是抗生素的广泛使用,大量治疗手段的开展,免疫障碍疾病的大量发生,使真菌感染的情况日益增加,医院感染中的真菌感染也不断增加,因而,掌握真菌检验的方法就成为检验工作中的一个重要组成部分。
1 材料与方法1.1 真菌来源收集临床送检标本所分离出的真菌120例,男性84例,女性36例,其中痰液96株,粪便11例,咽拭子12例、尿液5例、血液4例,分泌物3例。
1.2 采集及处理根据真菌侵犯组织和器官的不同而采集不同的标本,而采集最合适的标本是决定能否找到病原性真菌的关键,要尽量用消毒方法采集标本以免污染。
深部真菌病的标本如血液、脑脊液、脓液、尿、痰等应及时收集检查,一般不超过1~2h,以免变质污染,标本采取前,应忌用药。
为避免污染杂菌,在收集标本时,应严格无菌操作,必要时在培养基内加入抗生素类。
1.3 检验方法1.3.1 酵母样菌的检验直接涂片法各类标本,除脑脊液、尿、胸水、腹水等需离心沉淀后取沉淀物作涂片外,其他均可用生理盐水或10%~40%KOH作涂片后直接镜检或用革兰、墨汁、0.1%甲苯胺蓝染色后镜检。
分离酵母样菌所选用的培养基为沙保弱固体或液体培养基,在培养基中可加入各种抗生素抑制细菌的生长、有利于真菌生长含抑制剂的霉菌琼脂。
将备类标本直接接种上述培养基,除新型隐球菌需同时接种两支培养基;一支孵育于37℃,另一支孵育于22~28℃,其他酵母菌均孵育于22~28℃。
每日观察生长情况。
根据酵母菌在培养基上的菌落特征及在玉米粉吐温80培养基上生长物在显微镜下生长情况可作初步鉴定。
1.3.2 丝状真菌的检验某些丝状真菌如孢子丝菌或荚膜组织胞浆菌的直接涂片,必须染色后检查。
真菌的形态和结构通过染色更为清楚,不染色涂片不易保存,染色涂片可长期保存。

真菌分离及其抑菌性鉴定作者:唐先才来源:《现代商贸工业》2011年第05期摘要:本实验需重点研究的关键问题是怎样从几块不同的油菜地中取来土壤样品,然后把制作良好的培养基进行真菌分离纯化,运用形态学,理化方法鉴定出抑菌性真菌。
关键词:菌核;真菌;抑菌性;实验中图分类号:S6 文献标识码:A文章编号:1672-3198(2011)05-0289-01油菜菌核病又称菌核软腐病,俗称白杆、空杆、麻杆、烂杆、霉蔸等,是由油菜菌核病菌引起的一种真菌性病害。
防治主要采用农业防治、化学防治等综合防治的方法,虽然对生物防治的研究报道较多,但大部分研究结果仍然停留在实验室阶段,对于利用生防细菌防治的研究主要为筛选试验,对其防病机理缺乏深入研究。
本实验取样于不同油菜地的土壤进行病原物的分离与鉴定,弄清楚油菜地常见的几种真菌及其抑菌性,对于防治油菜相关病害很有意义。
1 实验内容采集油菜地的土壤进行真菌分离纯化,通过实验结果分析对比它们之间的真菌种类有什么大同小异,分离出的真菌对油菜的生长有什么样的影响,有没有使油菜致病。
1.1 实验过程(1)样本采集:采用五点采样法分别采集刚收获过后的菜地和表层1~35 cm深度范围内的土壤样品,充分混匀后取定量土壤样品制备土壤悬浮液。
(2)土壤悬浮液的制备:称取10g土壤置于盛有90mL无菌水的250 mL灭菌三角瓶内,充分振荡10min,制成10-1的稀释液,然后进行10倍倍比稀释至10-3。
(3)土壤真菌的分离:①制备加有氯霉素和孟加拉红的马丁琼脂培养基。
②用稀释平板法,此种方法在土壤真菌分离中最常用,用无菌水将土壤稀释后得到的悬浮液,将一定量稀释悬浮液均匀涂抹于培养基上,菌落长成后,将单个菌落挑出。
③培养:将接种土壤浮液的平板倒置于28°的温度区培养3-5天。
④挑菌纯化:从长有单菌落的平板中选取菌落转接斜面。
(4)真菌鉴定:真菌培养基采用马铃薯葡萄糖培养基。
①制备平板:将15-20毫升溶化后冷却到50度左右的培养基倒入培养皿中。

am真菌研究方法
AM真菌,也称为丛枝菌根真菌(Arbuscular Mycorrhizal Fungi),是一种与植物根系形成共生关系的土壤微生物。
它们在提高植物养分吸收、促进植物生长和抗逆性方面起着重要作用。
研究AM真菌的方法主要包括以下几个方面:
分离与纯化:从土壤中分离出AM真菌是纯化培养的第一步。
常用的方法包括湿筛法、蔗糖离心法和蔗糖梯度离心法等。
通过这些方法,可以从土壤中获得AM真菌的孢子、菌丝和菌根片段等。
培养与鉴定:将分离得到的AM真菌进行培养,观察其生长特性和菌落形态。
同时,采用分子生物学方法,如PCR扩增和序列分析,对AM真菌进行鉴定,确定其种类和遗传多样性。
生理生态学研究:研究AM真菌与植物的共生关系,需要了解其在不同生态环境下的生理生态特征。
这包括测定AM真菌对植物生长的促进作用、对土壤养分的吸收和利用效率、以及对逆境条件的响应等。
分子生物学技术研究:随着分子生物学技术的发展,越来越多的技术被应用于AM真菌的研究。
例如,实时荧光定量PCR技术可用于检测AM真菌在土壤中的数量;基因芯片技术可用于分析AM真菌的基因表达谱;高通量测序技术可用于揭示AM真菌的群落结构和多样性等。
总之,研究AM真菌需要综合运用多种方法和技术手段,从多个角度揭示其生态学和生理学特征,为深入理解AM真菌与植物的共生关系提供有力支持。
放线菌的分离与筛选方法放线菌(Actinomycetes)是一类革兰氏阳性细菌,常见于土壤和水体中。
由于其多样的形态和代谢特性,放线菌具有广泛的生物学和工业应用价值。
分离和筛选放线菌的方法是研究和利用其功能的基础,本文将介绍几种常用的方法。
一、分离方法:1.稀释和均匀涂布法:首先,将环境样品(如土壤、水样)进行适当稀释,并在培养基平板上平均涂布样品。
随着放线菌的生长,单个菌落会形成,然后可以通过挑选单个菌落进行分离纯化。
2.稀释和涂布法:方法类似于前者,但将初步培养得到的单菌落拖线在新的培养基平板上进行再次分离,以获得更纯的放线菌。
3.祛除污染菌法:样品前处理的关键是去除非放线菌细菌的干扰。
常见的处理方法有在分离培养基中加入抗生素、改变pH值等。
4.冷冻-融化法:利用放线菌对低温和高温的耐受性不同,将样品进行多次冻结-融化处理,可以选择性地分离出放线菌。
二、筛选方法:1.对抗菌活性筛选:放线菌具有对其他菌株的抗菌活性,可以使用对抗菌活性筛选方法,通过将待测分离物与感兴趣的致病菌共同培养,观察是否产生抑菌圈来筛选放线菌。
2.抗真菌筛选:放线菌不仅对细菌有抑制作用,也能抑制真菌的生长。
可以通过共培养放线菌和待测真菌,并观察是否产生抑菌圈来筛选放线菌。
3.溶磷筛选:放线菌具有溶解磷酸盐的能力,可以利用Na-P亚硝酸盐琼脂平板培养基来筛选放线菌。
4.产生生物活性化合物筛选:放线菌可以生成一系列生物活性化合物,如抗生素、酶、生物胺等。
可以根据需要设计相应的试剂盒,进行营养检测、酶活性测定或染色方法进行筛选。
5.双层平板筛选法:放线菌在液体培养基上生长一段时间后,将其转移到固体上层培养基上继续培养。
这种方法可以筛选出产生生物活性化合物的放线菌。
以上介绍的方法只是一小部分常用的放线菌分离和筛选方法,随着技术的不断发展,还有更多新的方法被提出。
分离和筛选放线菌是一个复杂且耗时的过程,需要根据具体的研究目的和条件来选择适合的方法。
常见真菌的分离与鉴定 发表时间:2010-08-20 发表者:皮肤科 (访问人次:361) 作者:上海长征医院皮肤科 徐红
2005年6月13~19日全国各地举行了第8届中国护足周,主题是“积极治疗足病,杜绝家庭传染”。
在中国,每2个人中就有1人罹患足病,其中成年人发病比例高达75%;超过60%的足病为真菌感染,其中足癣发病率为45.2%,甲真菌病(俗称甲癣)占15.5%;40%的足癣患者是被家人传染的;在真菌患者中只有23.8%寻求治疗,其中50%的患者症状稍有好转就不继续治疗。
真菌其实很常见,真菌就生活在我们身边。 病原真菌的一般特性 真菌(Fungi)是微生物中的一个大类,是一群数目庞大的细胞生物,估计全世界已有记载的真菌有10万种以上。它们的子实体小者用显微镜才能见到,大者可达数十厘米,它们共同特征是具有真正的细胞核,产生孢子和不含叶绿素,以寄生或腐生等方式吸取养料,仅少数类群为单细胞,其他都有分支或不分支的丝状体,能进行有性或无性繁殖,具有纤维素(或其他葡聚糖)或几丁质的微纤维或两者兼有的细胞壁的有机体。对人类和动物致病的真菌大约100余种,属于病原真菌。
一、基本性状 (一)形态结构 真菌分单细胞真菌与多细胞真菌两大类,前者属于酵母菌(yeast)一般呈球形或卵圆形,后者称为霉菌(mold)或丝状真菌,呈丝状分枝,菌丝交织象绒球状,另有一些真菌可因寄生环境及培养条件(养料、温度、氧气等)的不同可交替出现两种形态,即在室温中呈霉菌型,在37℃或体内呈单细胞的酵母型,这类真菌有双相性,所以称之为双态真菌或二相真菌。
真菌的细胞结构与一般植物细胞相似,有定型的细胞核及完善的细胞器,但胞壁与细菌胞壁不同,不含粘肽而是由角质及葡聚糖组成,也含有脂多糖蛋白质,其中酵母菌及类酵母菌皆以出芽增殖,不生长真菌丝,革兰氏染色呈阳性,丝状真菌分菌丝及孢子两部分,形态多种多样,分述如下。
1.菌丝(Hypha) 真菌在合适的环境中,由孢子生出嫩芽,称为芽管。芽管逐渐延长呈丝状,称菌丝。菌丝继续生长并生长分枝,增殖的菌丝交织组成菌丝体。其中一部分菌丝深入被寄生的物体或培养基中吸取养料,称为营养菌丝体。另一部分菌丝向空间生长,称为气生菌丝体。气生菌丝体能产生孢子
者称为生殖菌丝体。菌丝中各个细胞间有明显分隔者,称为有隔菌丝。主要见于病原性真菌。很多非病原真菌的菌丝无明显分隔,称为无隔菌丝。有些菌丝可呈各种特殊形式,如球拍状、破梳状、螺旋状、结节状、关节状、鹿角状、假菌丝。
2.孢子 生成孢子是真菌扩大繁殖的一种方式。真菌孢子的抵抗力、形态及作用等均与细菌芽胞不同,分为无性孢子及有性孢子两大类。不经过两性细胞的结合而形成的孢子叫无性孢子,这一繁殖过程称为无性繁殖。常见的无性孢子有5种:关节孢子、厚壁孢子、孢子囊孢子、芽孢和分生孢子。病原真菌属于不完全菌纲,很少产生有性孢子,大多数是无性孢子。
(1)厚壁孢子:当真菌在不利环境中,由菌丝内胞浆缩浓和胞壁增厚而成,呈圆形。当环境好转时可生成芽管成长为菌丝。
(2)关节孢子:菌丝断裂形成长方形两端略钝圆的孢子叫关节孢子。如白地霉和粗球孢子菌。
(3)孢子囊孢子:为鞭毛菌和接合菌的无性生殖形式。孢子囊中所含的孢子来源于分枝菌丝或胞囊梗顶端膨大形成孢子囊,囊内原生质浓缩集聚,割裂而成,一般数目较多,孢子囊形态多样,因种而异。
(4)芽生孢子:由菌细胞出芽生成,见于念珠菌及隐球菌,前者(类酵母菌)出芽后孢子伸长呈丝状,但不见与母细胞分离,称为假菌丝,在假菌丝上的收缩点也可出芽成芽生孢子。
(5)分生孢子:是子囊菌和半知菌的无性孢子,也是半知菌分类的主要依据,单细胞的分生孢子称小分生孢子,有蒂或无蒂,侧生或游离,分散或成群,圆形、梨形、卵圆形或其它形状,表面粗糙或光滑,或有或无各种纹饰。多细胞的分生孢子称大分生孢子,有纺锤形、棒形、球棍形、镰刀形及其它形状,两端尖或圆或一端圆,厚壁或薄壁,壁光滑或粗糙,有色或无色,分隔有多有少。
(二)培养特性及繁殖方式 1.培养特性 大多数真菌对营养要求不高,只需要水、盐,简单的氮源及碳水化合物就可生长,一般常用沙堡氏琼脂基(主要成分葡萄糖4%、蛋白胨1%、琼脂2%)培养都能生长。但需要弱酸性(pH 4~6)、较低孵育温度(22~28℃),充分温度和氧气供应才能生长良好。侵害内脏的某些真菌在37℃含血的培养基中生长良好。真菌生长都比较缓慢,大多需孵育数天后才成明显菌落,菌落有下列三种类型: (1)酵母型菌落:外观湿润稠软致密,类似一般细菌菌落,镜检只见有圆形或椭圆形生芽细胞(例如隐球菌的菌落)。 真菌的哪些特性决定了其有极强的生存能力? (2)类酵母型菌落:外观性状似酵母型菌落,镜检除见有出芽的细胞外,尚可见到假菌丝(例如念珠菌的菌落)。
(3)丝状型菌落:由多数分枝的菌丝体向上生长组成疏松的绒球状,表面有很多孢子,显示各种色泽,菌落可呈棉絮状 绒球状 粉末状或石膏样,其正面和背面可显示各种不同色素,常作为鉴定菌种的参考。镜检可见有纵横交织的菌丝及各种孢子(例如各种癣菌的菌落)。
2.繁殖方式 有多样性,包括出芽增殖,菌丝增长,菌丝分枝和断裂,产生无性孢子及有性孢子进行繁殖,因此它繁殖力很强,但生长速度较慢。
(三)变异性和抵抗力 真菌很容易发生变异,在人工培养基中多次移种或孵育过久,就可出现形态结构、菌落性状、色素以及各种生理性状(包括毒力)的改变,用不同的培养基和温度培养真菌,其性状也有改变,真菌对干燥阳光紫外线及一般化学消毒剂耐受性却较强。但对热的抵抗力却不强。60℃以上1小时即可杀死孢子及其菌丝,在1%~3%石炭酸、2.5%碘酊、0.1%升汞及10%甲醛中可被灭活。用甲醛气体熏蒸被真菌污染的衣物用具,可杀灭真菌菌丝及其孢子。但真菌对一般抗菌素及磺胺药均不敏感。只对二性霉素、酮康唑、制霉菌素等非常敏感,治疗真菌感染常用此药。
(四)致病性与免疫性 1.致病性 病原真菌的致病机制还是一个未完全解决的问题;根据其侵害部位,主要分为下列两类:
(1)浅部真菌病:主要由癣菌引起,大多为外源感染,常易侵害皮肤、指(趾)甲及须发等含角质的组织,引起癣症。
(2)深部真菌病:可由各种真菌引起,包括类酵母菌、二相真菌及丝状菌。侵害粘膜、皮下组织、内脏及脑膜等处,有时扩散全身,主要是内源性感染,也可由外源传染;前者是因机体抵抗力降低,如患重病,长期使用免疫抑制剂,广谱抗菌素或放射治疗,患恶性病,严重烧伤等时,造成体内菌群失调,以致常居在体内的某些真菌(如白念珠菌),甚至平时不致病的环境中的真菌(如曲霉、毛霉)等也会乘机侵害,一些传染性较强的内脏真菌病是内外源感染。
2.免疫性 浅部真菌病一般在血中不产生特异性抗体,病后无免疫保护力,只是儿童头癣等青春期后头皮皮脂增多时可以自愈,以后不再感染,其他部位癣症治愈后仍可再感染。深部真菌病虽可产生抗体,但无明显免疫保护作用。
三种癣菌从菌种鉴定上有何共同和不同之处?
临床常见的病原性真菌 一、 浅部真菌 (—)皮肤癣菌 皮肤癣菌又称皮肤丝状真菌,有下列三属(见表1),都只侵犯体表角化组织(皮肤,毛发及指甲和趾甲)。不侵害深部组织,或内脏,皆属外源性传染,由接触患癣病人、动物(狗、猫、鼠、牛、马等)或染菌物体而感染。
1.毛癣菌属 *红色毛癣菌 (1)直接镜检:皮屑及甲屑,分枝分隔的菌丝有时可断裂或关节孢子状,毛发:发外型感染表现为发外孢子排列成串。少数为发内型感染孢子在发内排列成链状;毛发穿孔试验阴性。 (2)培养特征:在葡萄糖蛋白胨琼脂,25℃,生长比较快,菌落形态有多种表现,镜检也不完全一样,常见有下列四种:I型:羊毛状:白色羊毛状菌丝充满斜面,典型的卷成筒状,边缘贴牢管壁,呈鲜红色,背面开始在中心有一红色小点,以后形成深红色环,最后成片为葡萄酒色,色素边缘划界非常明显。少数I型菌株表现无红色色素,正面白色,背面呈淡黄色类似石膏I型,亦有正面白色而背面呈灰黑色。II型:绒毛状:粉红色绒毛状菌丝生长,占斜面3/5,菌丝稀疏,透过菌丝可见粉红色的基底,背面颜色同I型相同。III型:粉未状:菌落表面稍有凸起,呈粉末状,粉红色,约占斜面的1/2~2/3,背面同I型。IV型:沟纹状:菌落生长相对较慢,比以上三种类型为小,占斜面的1/3~1/2,菌落中央凸起,从中央向四周有排列比较整齐的放射状沟纹,边缘整齐,表面菌丝甚少。开始微带黄色,以后变粉红,背面同I型。 (3)菌种鉴定:①菌落特征及色素;②大小分生孢子的形态;③玉米粉吐温琼脂上产生红色色素;④毛发穿孔试验阴性;⑤尿素酶试验阴性。 *须癣毛癣菌 (1)直接镜检:皮屑内见分枝分隔的菌丝,甲屑内为关节状菌丝。毛发感染为发外型,发内有时有菌丝。
(2)培养特性:在沙氏上生长较快,菌落形态可分为两大类:毛型和粉型;下列I、II型为毛型,III、IV、V型属粉型。自炎症明显的皮损中所分离出的菌株多属粉型。毛型菌落外观均似红毛,应注意鉴别。具体分型①羊毛状(I型),又称趾间毛癣菌,菌落生长快,白色羊毛状。气生菌丝较多且长,排列紧密,充满斜面,好象红毛,正面雪白,背面淡黄色。镜检见较细分枝,分隔的菌丝,胞浆浓。有少量球形或长形小分生孢子,无螺旋菌丝和大分生孢子。间或可见球拍菌丝及结节菌丝。②绒毛型(II型),生长快,菌落雪白。表面有紧密的细短气生菌丝,中央可有乳头状突起,边缘如刀切,背面棕黄色或棕红色。镜检见较细的分枝、分隔的菌丝,小分生孢子多,有时成葡萄串状,无螺旋菌丝或大分生孢子;③乳皮状(III型),开始为乳白色菌丝,不久一部分菌落变为粉末样,色微黄,光滑,似牛乳表面的一层薄膜,可一块块地挑取,中央有少许褶叠,边缘不整齐,背面淡黄或棕黄色。镜检见粗细不一,分枝分隔的菌丝和大量螺旋菌丝,间或可见破梳状菌丝,结节菌丝及球拍菌丝,大分生孢子少,棒状,两端圆,与分生孢子梗的连接处较窄,薄壁光滑,小分生孢子多,球形或长形,有时成葡萄串状排列。④粉末状(IV型),菌落粉末状,表面平坦、光滑。间或有少数白色气生菌丝,中央有乳头状凸起,边缘锯齿状。菌落生长快,充满斜面,色黄或奶油色,外观像石小、背面棕黄或棕红色。⑤颗粒状(V型):生长快,菌落粉样,表面不平,呈颗粒状。有不规则的褶叠或沟纹,边缘不整齐。下面色黄带红或棕黄。背面棕红色。IV、V镜检均见大量棒状大分生孢子及无数圆形的小分生孢子,少数长型。游离或葡萄状成串,有螺旋菌丝和球拍菌丝。